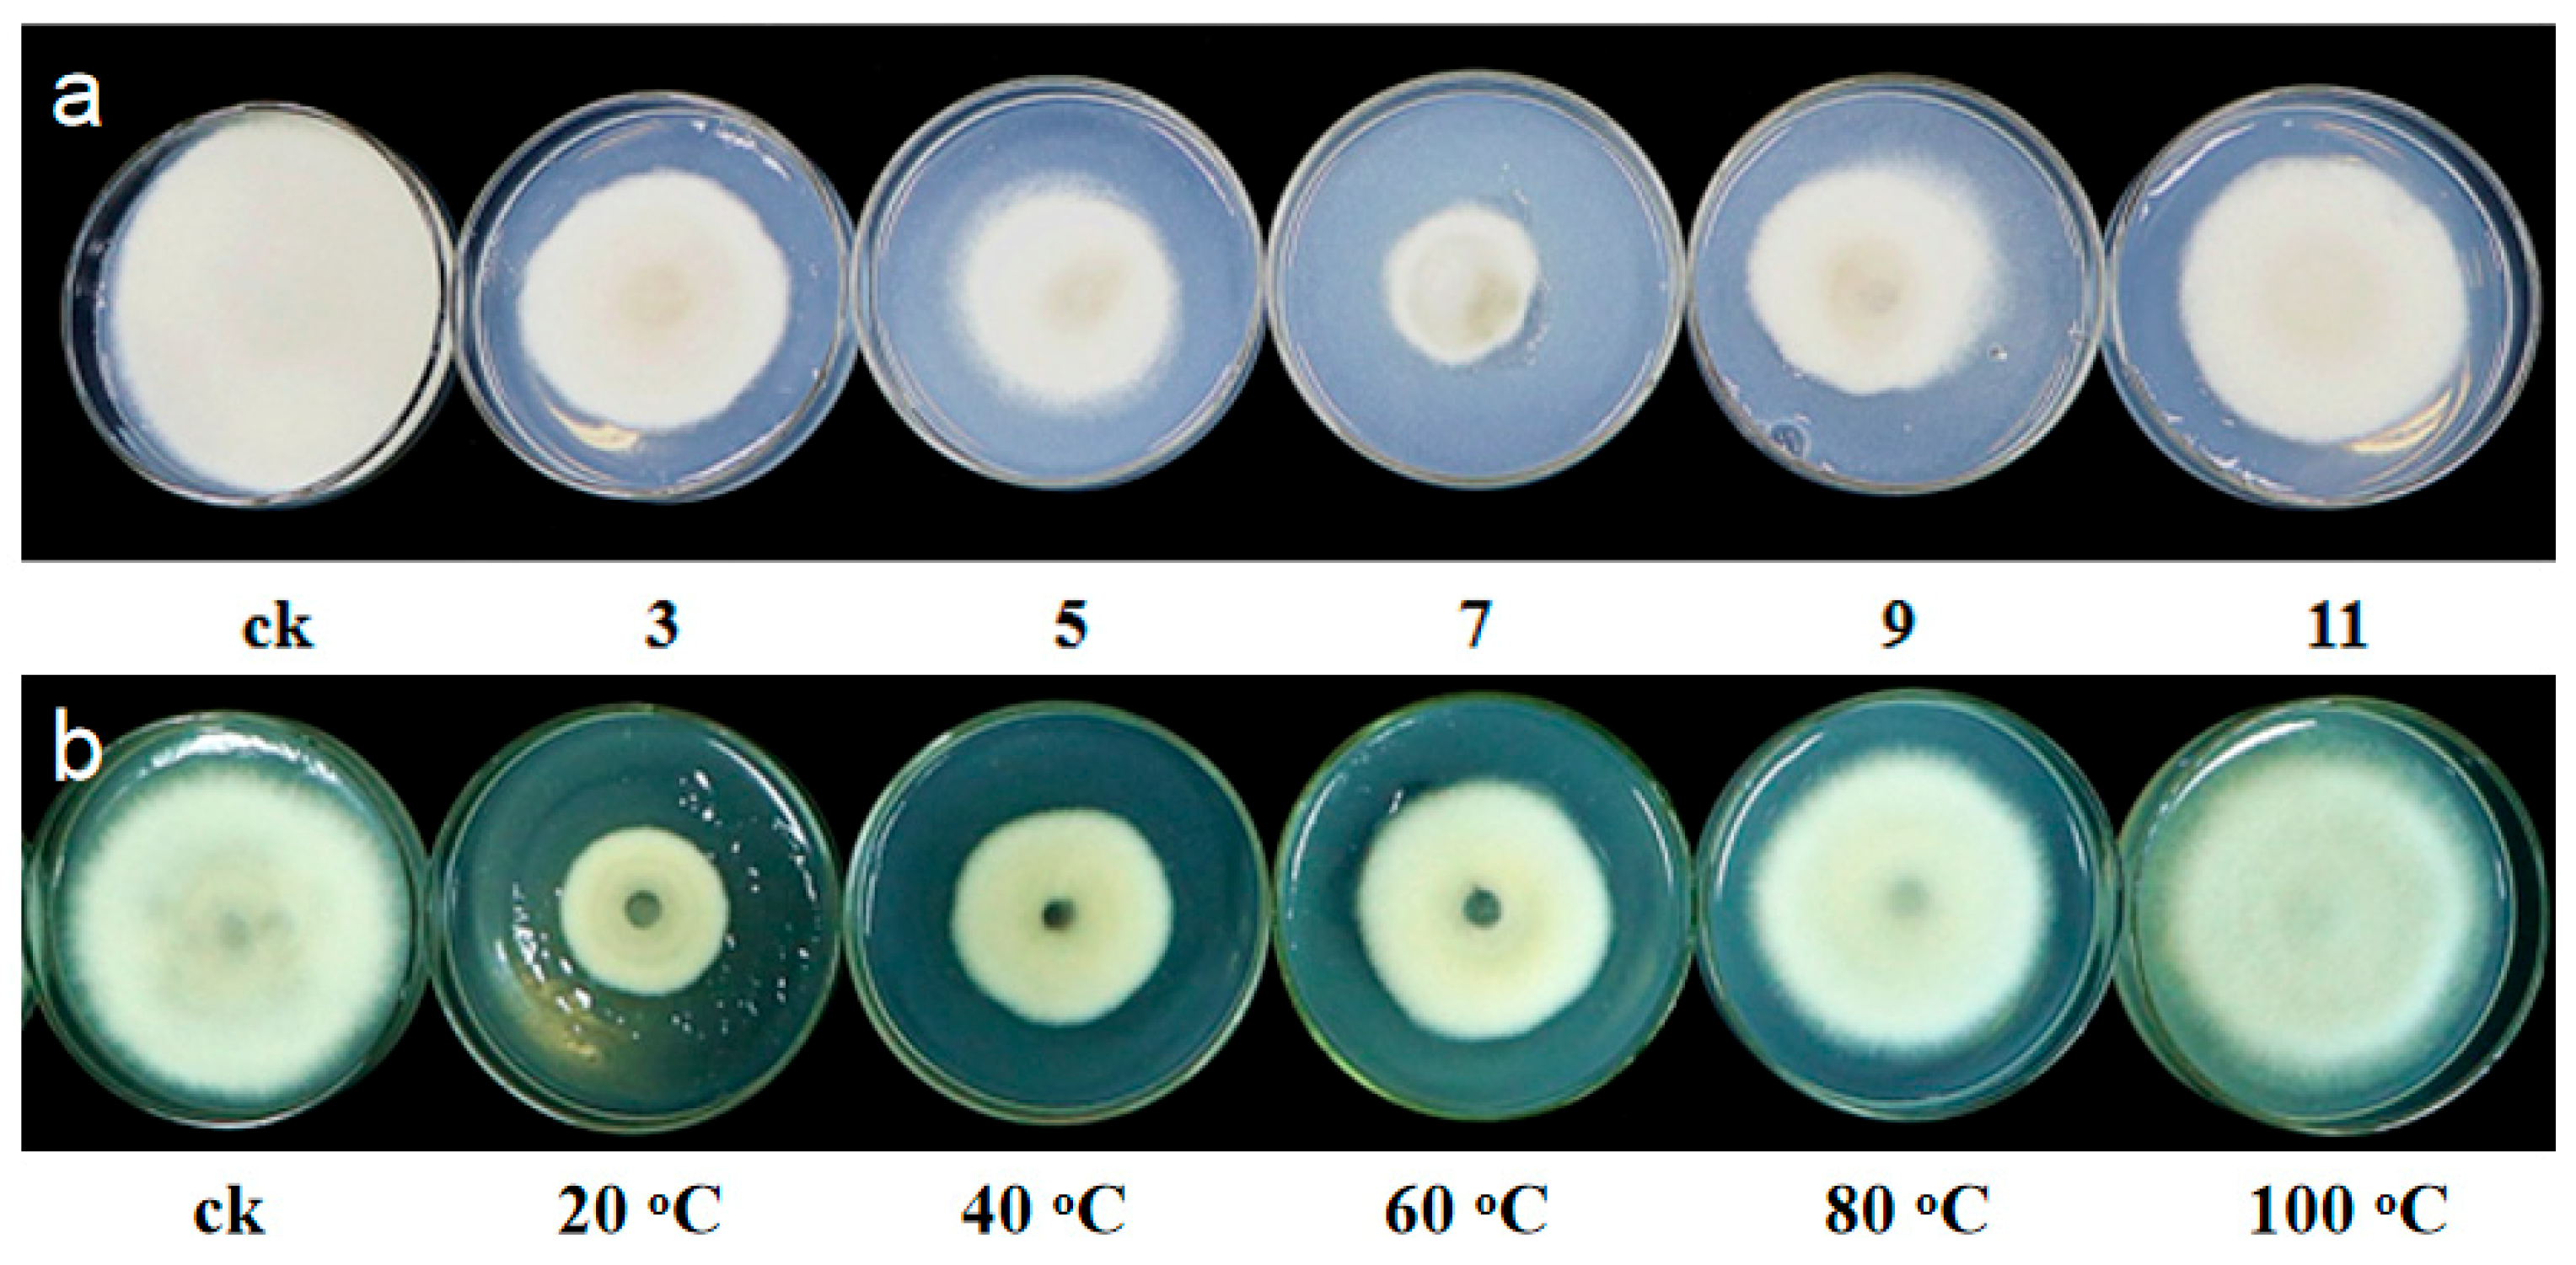
Microorganisms 07 00170 g005 Microorganisms 07 00170 g005

Characterization of Sinomonas gamaensis sp. nov., a Novel Soil Bacterium with Antifungal Activity against Exserohilum turcicum
Abstract
1. Introduction
2. Materials and Methods
2.1. Isolation of Bacterial Strain
2.2. Morphological and Biochemical Characteristics of NEAU-HV1T
2.3. Phylogenetic Analysis of NEAU-HV1
2.4. Chemotaxonomic Analysis of NEAU-HV1T
2.5. In Vitro Antifungal Activity Test
3. Results and Discussion
3.1. Polyphasic Taxonomic Characterization of NEAU-HV1T
3.2. Description of Sinomonas gamaensis sp. nov.
3.3. Antifungal Activity of NEAU-HV1T against E. turcicum
4. Conclusions
Supplementary Materials
Author Contributions
Funding
Conflicts of Interest
References
- Zhou, Y.; Wei, W.; Wang, X.; Lai, R. Proposal of Sinomonas flava gen. nov., sp. nov., and description of Sinomonas atrocyanea comb. nov. to accommodate Arthrobacter atrocyaneus. Int. J. Syst. Evol. Microbiol. 2009, 59, 259–263. [Google Scholar] [CrossRef] [PubMed]
- Zhou, Y.; Chen, X.; Zhang, Y.; Wang, W.; Xu, J. Description of Sinomonas soli sp. nov., reclassification of Arthrobacter echigonensis and Arthrobacter albidus (Ding et al. 2009) as Sinomonas echigonensis comb. nov. and Sinomonas albida comb. nov., respectively, and emended description of the genus Sinomonas. Int. J. Syst. Evol. Microbiol. 2012, 62, 764–769. [Google Scholar] [PubMed]
- Zhang, M.Y.; Xie, J.; Zhang, T.Y.; Xu, H.; Cheng, J.; Li, S.H.; Li, W.J.; Zhang, Y.X. Sinomonas notoginsengisoli sp. nov., isolated from the rhizosphere of Panax notoginseng. Antonie van Leeuwenhoek 2014, 106, 827–835. [Google Scholar] [CrossRef] [PubMed]
- Prabhu, D.M.; Quadri, S.R.; Cheng, J.; Liu, L.; Chen, W.; Yang, Y.; Hozzein, W.N.; Lingappa, K.; Li, W.J. Sinomonas mesophila sp. nov., isolated from ancient fort soil. J. Antibiot. 2015, 68, 318–321. [Google Scholar] [CrossRef] [PubMed]
- Bao, Y.Y.; Huang, Z.; Mao, D.M.; Sheng, X.F.; He, L.Y. Sinomonas susongensis sp. nov., isolated from the surface of weathered biotite. Int. J. Syst. Evol. Microbiol. 2015, 65, 1133–1137. [Google Scholar] [CrossRef] [PubMed]
- Guo, Q.Q.; Ming, H.; Meng, X.L.; Huang, J.R.; Duan, Y.Y.; Li, S.H.; Li, S.; Zhang, J.X.; Li, W.J.; Nie, G.X. Sinomonas halotolerans sp. nov., an actinobacterium isolated from a soil sample. Antonie van Leeuwenhoek 2015, 108, 887–895. [Google Scholar] [CrossRef]
- Lee, L.H.; Azman, A.S.; Zainal, N.; Yin, W.F.; Ab Mutalib, N.S.; Chan, K.G. Sinomonas humi sp. nov., an amylolytic actinobacterium isolated from mangrove forest soil. Int. J. Syst. Evol. Microbiol. 2015, 65, 996–1002. [Google Scholar] [CrossRef]
- Manikprabhu, D.; Cheng, J.; Chen, W.; Sunkara, A.K.; Mane, S.B.; Kumar, R.; das, M.; NHozzein, W.; Duan, Y.Q.; Li, W.J. Sunlight mediated synthesis of silver nanoparticles by a novel actinobacterium (Sinomonas mesophila MPKL 26) and its antimicrobial activity against multi drug resistant Staphylococcus aureus. J. Photochem. Photobiol. B 2016, 158, 202–205. [Google Scholar] [CrossRef]
- Ser, H.L.; Tan, W.S.; Cheng, H.J.; Yin, W.F.; Chan, K.G.; Lee, L.H. Draft genome of amylolytic actinobacterium, Sinomonas humi MUSC 117T isolated from intertidal soil. Mar. Genom. 2015, 24, 209–210. [Google Scholar] [CrossRef]
- Mishra, S.; Panda, P.P.; Pradhan, N.; Satapathy, D.; Subudhi, U.; Biswal, S.K.; Mishra, B.K. Effect of native bacteria Sinomonas flava 1C and Acidithiobacillus ferrooxidans on desulphurization of Meghalaya coal and its combustion properties. Fuel 2014, 117, 415–421. [Google Scholar] [CrossRef]
- Kumano, T.; Fujiki, E.; Hashimoto, Y.; Kobayashi, M. Discovery of a sesamin-metabolizing microorganism and a new enzyme. Proc. Natl. Acad. Sci. USA 2016, 113, 9087–9092. [Google Scholar] [CrossRef] [PubMed]
- Adhikari, M.; Yadav, D.R.; Kim, S.W.; Um, Y.H.; Kim, H.S.; Lee, S.C.; Song, J.Y.; Kim, H.G.; Lee, Y.S. Biological control of bacterial fruit blotch of watermelon pathogen (Acidovorax citrulli) with rhizosphere associated bacteria. Plant Pathol. J. 2017, 33, 170–183. [Google Scholar] [CrossRef] [PubMed]
- Hayakawa, M.; Nonomura, H. Humic acid-vitamin agar, a new medium for selective isolation of soil actinomycetes. J. Ferment. Technol. 1987, 65, 501–509. [Google Scholar] [CrossRef]
- Leifson, E. Atlas of Bacterial Flagellation; Academic Press: Cambridge, MA, USA, 1960. [Google Scholar]
- Skerman, V.B.D. A Guide to the Identification of the Genera of Bacteria, 2nd ed.; Williams & Wilkins: Philadelphia, PA, USA, 1967. [Google Scholar]
- Smibert, R.M.; Krieg, N.R. Phenotypic characterization. In Methods for General and Molecular Bacteriology; Gerhardt, P., Murray, R.G.E., Woalod, W.A., Krieg, N.R., Eds.; American Society for Microbiology: Washington, DC, USA, 1994; pp. 607–654. [Google Scholar]
- Fu, Y.; Yan, R.; Liu, D.; Jiang, S.; Cui, L.; Guo, X.; Wang, X.; Zhang, J.; Xiang, W. Trinickia diaoshuihuensis sp. nov., a plant growth promoting bacterium isolated from soil. Int. J. Syst. Evol. Microbiol. 2019, 69, 291–296. [Google Scholar] [CrossRef] [PubMed]
- Ventosa, A.; Quesada, E.; Rodriguez Valera, F.; Ruiz Berraquero, F.; Ramos Cormenzana, A. Numerical taxonomy of moderately halophilic gram-negative rods. Microbiology 1982, 128, 1959–1968. [Google Scholar] [CrossRef]
- Yan, R.; Fu, Y.; Liu, D.; Jiang, S.; Ju, H.; Guo, X.; Guo, X.; Wang, X.; Zhang, J.; Xiang, W. Arthrobacter silvisoli sp. nov., isolated from forest soil. Int. J. Syst. Evol. Microbiol. 2018, 68, 3892–3896. [Google Scholar] [CrossRef] [PubMed]
- Yoon, S.H.; Ha, S.M.; Kwon, S.; Lim, J.; Kim, Y.; Seo, H.; Chun, J. Introducing EzBioCloud: A taxonomically united database of 16S rRNA gene sequences and whole-genome assemblies. Int. J. Syst. Evol. Microbiol. 2017, 67, 1613–1617. [Google Scholar] [PubMed]
- Saitou, N.; Nei, M. The neighbor-joining method: A new method for reconstructing phylogenetic trees. Mol. Biol. Evol. 1987, 4, 406–425. [Google Scholar]
- Felsenstein, J. Evolutionary trees from DNA sequences: A maximum likelihood approach. J. Mol. Evol. 1981, 17, 368–376. [Google Scholar] [CrossRef]
- Rzhetsky, A.; Nei, M. A simple method for estimating and testing minimum evolution trees. Mol. Biol. Evol. 1992, 9, 945–967. [Google Scholar]
- Kumar, S.; Stecher, G.; Tamura, K. MEGA7: Molecular evolutionary genetics analysis version 7.0 for bigger datasets. Mol. Biol. Evol. 2016, 33, 1870–1874. [Google Scholar] [CrossRef] [PubMed]
- Kimura, M. A simple method for estimating evolutionary rates of base substitutions through comparative studies of nucleotide sequences. J. Mol. Evol. 1980, 16, 111–120. [Google Scholar] [CrossRef] [PubMed]
- Felsenstein, J. Confidence limits on phylogenies: An approach using the bootstrap. Evolution 1985, 39, 783–791. [Google Scholar] [CrossRef] [PubMed]
- Li, R.; Li, Y.; Kristiansen, K.; Wang, J. SOAP: Short oligonucleotide alignment program. Bioinformatics 2008, 24, 713–714. [Google Scholar] [CrossRef] [PubMed]
- Meier-Kolthoff, J.P.; Auch, A.F.; Klenk, H.P.; Göker, M. Genome sequence-based species delimitation with confidence intervals and improved distance functions. BMC Bioinform. 2013, 14, 60. [Google Scholar] [CrossRef] [PubMed]
- Yoon, S.H.; Ha, S.M.; Lim, J.; Kwon, S.; Chun, J. A large-scale evaluation of algorithms to calculate average nucleotide identity. Antonie van Leeuwenhoek 2017, 110, 1281–1286. [Google Scholar] [CrossRef] [PubMed]
- Richter, M.; Rosselló-Móra, R.; Oliver Glöckner, F.; Peplies, J. JSpeciesWS: A web server for prokaryotic species circumscription based on pairwise genome comparison. Bioinformatics 2016, 32, 929–931. [Google Scholar] [CrossRef] [PubMed]
- Chaudhari, N.M.; Gupta, V.K.; Dutta, C. BPGA—An ultra-fast pan-genome analysis pipeline. Sci. Rep. 2016, 6, 24373. [Google Scholar] [CrossRef]
- Blin, K.; Wolf, T.; Chevrette, M.G.; Lu, X.; Schwalen, C.J.; Kautsar, S.A.; Suarez Duran, H.G.; de Los Santos, E.L.C.; Kim, H.U.; Nave, M.; et al. antiSMASH 4.0—Improvements in chemistry prediction and gene cluster boundary identification. Nucleic Acids Res. 2017, 45, W36–W41. [Google Scholar] [CrossRef]
- McKerrow, J.; Vagg, S.; McKinney, T.; Seviour, E.M.; Maszenan, A.M.; Brooks, P.; Seviour, R.J. A simple HPLC method for analysing diaminopimelic acid diastereomers in cell walls of Gram-positive bacteria. Lett. Appl. Microbiol. 2000, 30, 178–182. [Google Scholar] [CrossRef]
- Tang, S.K.; Wang, Y.; Chen, Y.; Lou, K.; Cao, L.L.; Xu, L.H.; Li, W.J. Zhihengliuella alba sp. nov., and emended description of the genus Zhihengliuella. Int. J. Syst. Evol. Microbiol. 2009, 59, 2025–2032. [Google Scholar] [CrossRef] [PubMed]
- Minnikin, D.E.; O’Donnell, A.G.; Goodfellow, M.; Alderson, G.; Athalye, M.; Schaal, A.; Parlett, J.H. An integrated procedure for the extraction of bacterial isoprenoid quinones and polar lipids. J. Microbiol. Methods 1984, 2, 233–241. [Google Scholar] [CrossRef]
- Collins, M.D. Isoprenoid quinone analyses in bacterial classification and identification. In Chemical Methods in Bacterial Systematics; Goodfellow, M., Minnikin, D.E., Eds.; Academic Press: Cambridge, MA, USA, 1985; pp. 267–284. [Google Scholar]
- Wu, C.; Lu, X.; Qin, M.; Wang, Y.; Ruan, J. Analysis of menaquinone compound in microbial cells by HPLC. Microbiology 1989, 16, 176–178. [Google Scholar]
- Xiang, W.; Liu, C.; Wang, X.; Du, J.; Xi, L.; Huang, Y. Actinoalloteichus nanshanensis sp. nov., isolated from the rhizosphere of a fig tree (Ficus religiosa). Int. J. Syst. Evol. Microbiol. 2011, 61, 1165–1169. [Google Scholar] [CrossRef] [PubMed]
- Wang, C.; Zhang, Y.; Zhang, W.; Yuan, S.; Ng, T.; Ye, X. Purification of an antifungal peptide from seeds of Brassica oleracea var. gongylodes and investigation of its antifungal activity and mechanism of action. Molecules 2019, 24, 1337. [Google Scholar] [CrossRef]
- Iwami, M.; Nakayama, O.; Terano, H.; Kohsaka, M.; Aoki, H.; Imanaka, H. A new immunomodulator, FR-900494: Taxonomy, fermentation, isolation, and physico-chemical and biological characteristic. J. Antibiot. 1987, 40, 612–622. [Google Scholar] [CrossRef]
- Magaldi, S.; Mata-Essayag, S.; de Capriles, C.H.; Perez, C.; Colella, M.T.; Olaizola, C.; Ontiveros, Y. Well diffusion for antifungal susceptibility. Int. J. Infect. Dis. 2004, 8, 39–45. [Google Scholar] [CrossRef]
- Richter, M.; Rosselló Móra, R. Shifting the genomic gold standard for the prokaryotic species definition. Proc. Natl. Acad. Sci. USA 2009, 106, 19126–19131. [Google Scholar] [CrossRef]

| Characteristic | NEAU-HV1T | S. susongensis A31T | S. albida LC13T | S. humi MUSC 117T |
|---|---|---|---|---|
| Nitrate reduction | + | ‒ | + | ‒ |
| Production of urease | + | + | ‒ | ‒ |
| Hydrolysis of Starch | ‒ | ‒ | + | ‒ |
| Citrate utilization | + | + | ‒ | + |
| Voges–Proskauer reaction | + | + | + | ‒ |
| Utilization of: | ||||
| L-Tyrosine | + | ‒ | + | ‒ |
| L-Glycine | ‒ | + | + | + |
| L-Arginine | + | ‒ | + | + |
| L-Threonine | + | ‒ | + | ‒ |
| L-Alanine | + | + | + | ‒ |
| Creatine | ‒ | + | ‒ | + |
| Raffinose | + | ‒ | + | + |
| L-Rhamnose | + | + | + | ‒ |
| D-Mannitol | ‒ | + | + | ‒ |
| Inositol | ‒ | ‒ | + | ‒ |
| L-Arabinose | + | + | ‒ | ‒ |
| D-Xylose | + | + | + | ‒ |
| Lactose | + | ‒ | + | ‒ |
| D-Fructose | + | ‒ | + | ‒ |
| D-Galactitol | ‒ | + | + | + |
| D-Galactose | + | + | + | ‒ |
| G+C mol% | 67.64 | 68.64 | 69.46 | 67.16 |
| Features | Values |
|---|---|
| Genome size (bp) | 4,320,429 |
| DNA G+C (%) | 67.64 |
| Number of contigs | 39 |
| Number of CDS | 4182 |
| RNA genes | 46 |
| rRNA | 3 |
| tRNA | 43 |
| N50 (bp) | 233,829 |
| N90 (bp) | 55,667 |
| Numbers of genomics islands | 11 |
| Numbers of prophage | 3 |
| Numbers of CRISPR | 3 |
| Strains | DDH (%) | OrthoANIu | ANIm | ANIb |
|---|---|---|---|---|
| S. susongensis A31T | 23.20 | 80.23 | 85.16 | 79.34 |
| S. albida LC13T | 23.50 | 80.08 | 85.49 | 79.45 |
| S. humi MUSC 117T | 22.80 | 79.72 | 85.17 | 78.94 |
| Fatty Acid | NEAU-HV1T | S. susongensis A31T | S. albidus LC13T | S. humi MUSC 117T |
|---|---|---|---|---|
| Iso-C15:0 | 7.9 | 12.1 | 13.5 | 8.8 |
| Anteiso-C15:0 | 44.6 | 55.2 | 39.2 | 41.4 |
| C16:0 | 20.5 | 3.5 | 2.1 | 1.8 |
| Iso-C16:0 | – | 2.7 | 7.8 | 12.7 |
| Anteiso-C17:0 | 26.9 | 22.8 | 29.4 | 16.2 |
| Iso-C17:0 | – | 2.6 | 5.9 | 1.3 |
| C18:1ω7c | – | – | – | 16.2 |
© 2019 by the authors. Licensee MDPI, Basel, Switzerland. This article is an open access article distributed under the terms and conditions of the Creative Commons Attribution (CC BY) license (http://creativecommons.org/licenses/by/4.0/).
Share and Cite
Fu, Y.; Yan, R.; Liu, D.; Zhao, J.; Song, J.; Wang, X.; Cui, L.; Zhang, J.; Xiang, W. Characterization of Sinomonas gamaensis sp. nov., a Novel Soil Bacterium with Antifungal Activity against Exserohilum turcicum. Microorganisms 2019, 7, 170. https://doi.org/10.3390/microorganisms7060170
Fu Y, Yan R, Liu D, Zhao J, Song J, Wang X, Cui L, Zhang J, Xiang W. Characterization of Sinomonas gamaensis sp. nov., a Novel Soil Bacterium with Antifungal Activity against Exserohilum turcicum. Microorganisms. 2019; 7(6):170. https://doi.org/10.3390/microorganisms7060170
Chicago/Turabian StyleFu, Yansong, Rui Yan, Dongli Liu, Junwei Zhao, Jia Song, Xiangjing Wang, Lin Cui, Ji Zhang, and Wensheng Xiang. 2019. "Characterization of Sinomonas gamaensis sp. nov., a Novel Soil Bacterium with Antifungal Activity against Exserohilum turcicum" Microorganisms 7, no. 6: 170. https://doi.org/10.3390/microorganisms7060170
APA StyleFu, Y., Yan, R., Liu, D., Zhao, J., Song, J., Wang, X., Cui, L., Zhang, J., & Xiang, W. (2019). Characterization of Sinomonas gamaensis sp. nov., a Novel Soil Bacterium with Antifungal Activity against Exserohilum turcicum. Microorganisms, 7(6), 170. https://doi.org/10.3390/microorganisms7060170
